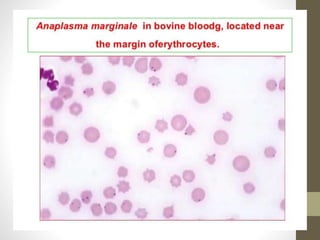

The document outlines the preparation, fixation, and staining methods for blood smears to investigate hematological disorders and detect parasites. It details various techniques for creating thin and thick blood films, fixing the smear, and using specific stains like Leishman and Giemsa for microscopic examination. Key factors affecting smear quality and common mistakes are also discussed, alongside methods to avoid and correct them.